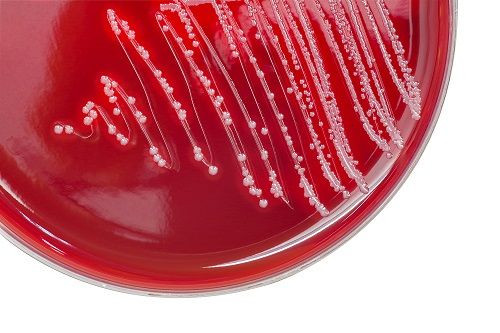

Healthcare Associated Infections (HAI)
Latest News

Latest Videos
CME Content
More News

Contagion® will be covering the conference, and so keep a look out for session coverage, as well as interviews with some of the key presenters.

A multi-institution research team has found that daptomycin is effective and well-tolerated in children.

Duke Health researchers have found that a UVC machine use can reduce transmission of harmful superbugs in hospital settings.

As emerging infectious diseases and resistant bugs become a growing issue, the need for stronger disinfectants becomes even more vital.

As healthcare-associated infections continue to be life-threatening, Clorox Healthcare continues to provide bacteria- and virus-killing products that aim to reduce the risk of infection.

On March 5, 2017, at the 2017 Annual Meeting of the American Academy of Allergy, Asthma & Immunology (AAAAI), Gary Huang, MD, PhD, explained his research team's findings regarding self-reported allergy to drugs containing β-lactams.

A recent study from the researchers at the University of Virginia has provided insight into how multidrug-resistant bacteria living in sink drainpipes can spread in hospitals.

Robin Jump, MD, PhD, assistant professor in the Department of Medicine at the Case Western Reserve University sat down with Contagion™ to discuss up-and-coming prevention methods for C. diff in the hospital setting.

The Centers for Disease Control and Prevention recently investigated three incidents of rare microsporidiosis infections in transplant patients in the United States.

NIH scientists have, for the first time, linked a Staphylococcus epidermidis toxin, called PSM-mec, with sepsis.

Researchers found the experimental vaccine could potentially inhibit severe diarrhea and pseudomembranous colitis by inducing a functional antibody response that can neutralize the two main disease-causing toxins (toxin A or B) produced by C. difficile.

The ECDC has released a software toolkit that can calculate the disability-adjusted life years for a number of infectious diseases and healthcare-associated infections.


This article is the second part of two-part coverage on a study conducted by Rutgers University researchers that analyzes the effects of misdiagnosing fungal infections on the increasing rates of antimicrobial resistance.

A recent study conducted by Rutgers University researchers analyzes the effects of misdiagnosing fungal infections on the increasing rates of antimicrobial resistance.

Researchers from Massachusetts have found that carbapenem-resistant Enterobacteriaceae have more genetic traits that enable antibiotic-resistance than previously thought and these traits are easily transferred among species.

These findings discredit previous allegations that this outbreak was the cause of one source and that the number of cases is higher than that identified in previous years.

A new study has provided more evidence to show that certain heartburn medications may make individuals more susceptible to gastrointestinal infections.

University of Connecticut researchers have developed novel antibiotic compounds to target methicillin-resistant Staphylococcus aureus infections, offering a potential new drug in the fight against this pathogen.

Researchers uncover high rates of co-infections in patients who are admitted to hospitals with influenza.

Seeking to improve the nation’s health and safety, the Centers for Disease Control and Prevention (CDC) has been targeting several high-burden issues in which it could make the greatest impact, and three such issues are infectious diseases.

A new study takes a look at the efficacy of off-label treatments for Clostridium difficile (C. difficile) infection.



Under a program established through the Affordable Care Act, 769 US hospitals will receive Medicare reimbursement reductions due to the high rates of hospital-acquired infections.